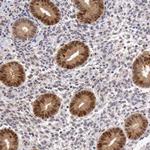
FAM122B Antibody in Immunohistochemistry (Paraffin) (IHC (P))

Search
Invitrogen
FAM122B Polyclonal Antibody
{{$productOrderCtrl.translations['antibody.pdp.commerceCard.promotion.promotions']}}
{{$productOrderCtrl.translations['antibody.pdp.commerceCard.promotion.viewpromo']}}
{{$productOrderCtrl.translations['antibody.pdp.commerceCard.promotion.promocode']}}: {{promo.promoCode}} {{promo.promoTitle}} {{promo.promoDescription}}. {{$productOrderCtrl.translations['antibody.pdp.commerceCard.promotion.learnmore']}}
产品信息
PA5-51371
种属反应
宿主/亚型
分类
类型
抗原
偶联物
形式
浓度
规格
纯化类型
保存液
内含物
保存条件
运输条件
RRID
产品详细信息
Immunogen sequence: EPDTSYGGTL RRSSSAPLIH GLSDLSQVFQ PYTLRTRRNS TTIMSRHSLE EGLDMVNRET AHEREMQTAM QISQSWDESL SLSDSDFDKP EKLYSPKRID FTPVSPAPSP TRGFGKMFVS SS
Highest antigen sequence identity to the following orthologs: Mouse - 81%, Rat - 81%.
靶标信息
FAM122B (Family with Sequence Similarity 122 Member B) is a gene located on chromosome 9 that encodes a protein involved in cellular signaling and regulation. FAM122B is known to interact with protein phosphatase 2A (PP2A), a critical enzyme in multiple signaling pathways, thereby impacting various cellular functions such as growth, division, and apoptosis. This interaction is pivotal for the modulation of PP2A activity, which in turn influences numerous downstream signaling processes. Studies have indicated that FAM122B may play a role in cancer biology, particularly in the regulation of oncogenic pathways. Dysregulation of FAM122B expression has been observed in certain cancers, suggesting its potential involvement in tumor progression and as a biomarker for diagnosis or prognosis. Furthermore, the gene's expression patterns indicate its importance in normal cellular homeostasis and the maintenance of cellular signaling balance.
仅用于科研。不用于诊断过程。未经明确授权不得转售。
篇参考文献 (0)
生物信息学
蛋白别名: erg-3; ets-related; family with sequence similarity 122B; p55; PABIR family member 2; protein FAM122B; synoviocyte proliferation associated in collagen-induced arthritis 2; TMPRSS2/ERG fusion; unnamed protein product
基因别名: FAM122B; PABIR2; SPACIA2
UniProt ID: (Human) Q7Z309
Entrez Gene ID: (Human) 159090